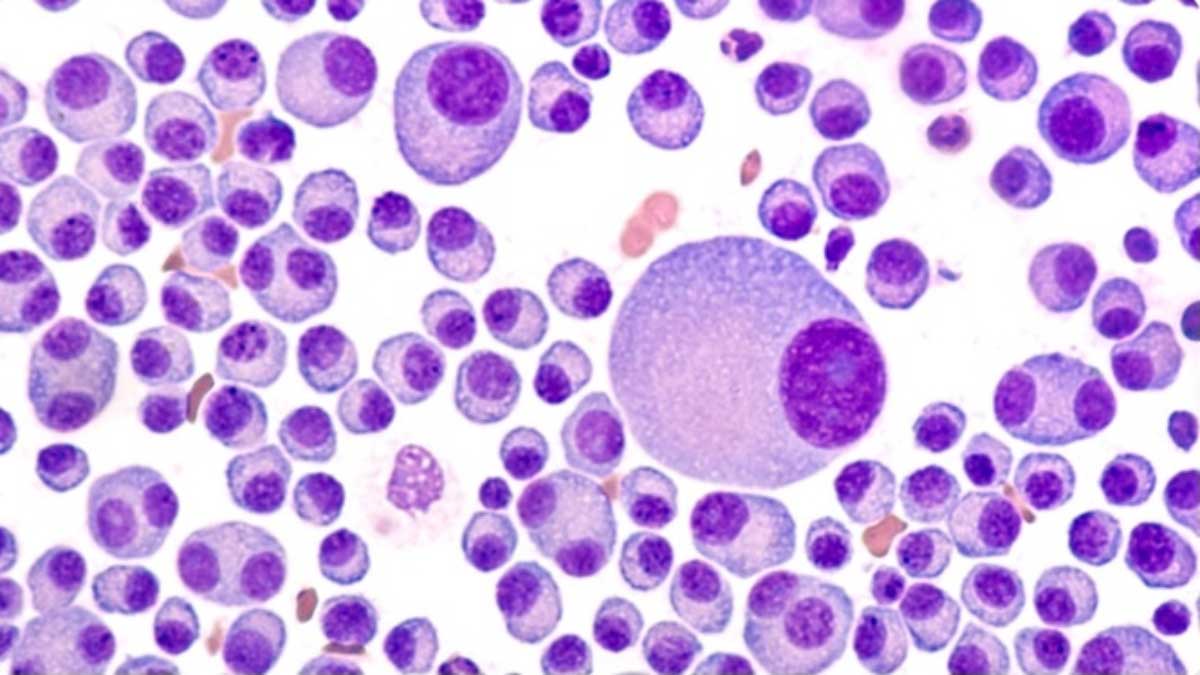
πολλαπλό μυέλωμα

Σεξουαλική δυσλειτουργία σε ασθενείς με πολλαπλό μυέλωμα
Το πολλαπλό μυέλωμα είναι ένας καρκίνος του αίματος ο οποίος ξεκινάει από έναν κλώνο πλασματοκυττάρων. Το πολλαπλό μυέλωμα έχει σημαντική νοσηρότητα και θνητότητα και προκαλεί βλάβες σε πολλά όργανα (νεφρική ανεπάρκεια, υπερασβεστιαιμία, οστεολυτικές βλάβες, αναιμία).
Η θεραπεία του πολλαπλού μυελώματος έχει βελτιωθεί σημαντικά τα τελευταία χρόνια και μια ασθένεια που ήταν ανίατη, τώρα αντιμετωπίζεται ακόμα και χωρίς νοσηλεία. Η πρώτη σημαντική εξέλιξη στη θεραπεία του πολλαπλού μυελώματος ήταν η αυτόλογη μεταμόσχευση βλαστοκυττάρων τη δεκαετία του 1980 και 1990. Στις αρχές του 21ου αιώνα εξελίχθηκαν τα ανοσοτροποποιητικά φάρμακα της τάξης των ιμιδίων (IMID, θαλιδομίδη και λεναλιδομίδη/Revlimid) και οι αναστολείς πρωτεωσώματος (βορτεζομίμπη/Velcadel, ιξαζομίμπη). Πρόσφατα πήραν έγκριση για τη θεραπεία του πολλαπλού μυελώματος μονοκλωνικά αντισώματα όπως η δαρατουμουμάμπη (Darzalex) και η ελοτουζουμάμπη και αναστολείς της αποακετυλάσης των ιστονών όπως η πανομπινοστάτη (Farydak). Η επιλογή της θεραπείας εξαρτάται από την γενική υγεία του ασθενή. Στους νεοδιαγνωσμένους ασθενείς με πολλαπλό μυέλωμα που είναι κάτω από 70 ετών με καλή κατάσταση υγείας προτιμάται μια τριπλή αγωγή νεώτερων φαρμάκων ακολουθούμενη από αυτόλογη μεταμόσχευση βλαστοκυττάρων.
Η σεξουαλική δυσλειτουργία είναι ένα σύμπτωμα που αναφέρεται συχνά από ασθενείς που έχουν επιβιώσει από καρκίνο και ιδίως από αυτούς που έχουν υποβληθεί σε χημειοθεραπεία και/ή ακτινοθεραπεία. Οι σεξουαλικές επιπλοκές έχουν μελετηθεί εκτενώς στον καρκίνο του προστάτη, του μαστού και των γεννητικών οργάνων αλλά πολύ λιγότερο στους καρκίνους του αίματος.
Οι σεξουαλικές διαταραχές περιλαμβάνουν μειωμένη σεξουαλική επιθυμία, μειωμένη λίπανση του κόλπου, αδυναμία επίτευξης οργασμού, πόνος στη σεξουαλική επαφή και στυτική δυσλειτουργία. Η σεξουαλική δυσλειτουργία ορίζεται ως πρωτοπαθής όταν προκύπτει από επιπλοκές του πολλαπλού μυελώματος και της θεραπείας όπως ορμονικές διαταραχές, νεφρική ανεπάρκεια και σακχαρώδης διαβήτης. Η δευτεροπαθής σεξουαλική δυσλειτουργία οφείλεται σε συμπτώματα του πολλαπλού μυελώματος όπως αδυναμία, κόπωση και πόνος. Η τριτοπαθής σεξουαλική δυσλειτουργία οφείλεται σε συναισθηματικούς και ψυχολογικούς λόγους όπως η κατάθλιψη, ο φόβος και η αρνητική ιδέα για την εικόνα του σώματος.
Επιπλοκές της θεραπείας για πολλαπλό μυέλωμα.
Η παραδοσιακή χημειοθεραπεία με αλκυλιούντες παράγοντες, αλκαλοειδή της Vinca και παράγοντες της πλατίνης έχει τεκμηριωμένη επίδραση στη σεξουαλική λειτουργία των καρκινοπαθών. Η κυκλοφωσφαμίδη και η μελφαλάνη προκαλούν υπογονιμότητα σε γυναίκες και άντρες. Ο συνδυασμός μελφαλάνης και αυτόλογης μεταμόσχευσης βλαστοκυττάρων προκαλεί πρόωρη εμμηνόπαυση σε νεαρές γυναίκες με συναισθηματικές, ψυχολογικές και σεξουαλικές επιπτώσεις. Η αυτόλογη μεταμόσχευση βλαστικών κυττάρων σχετίζεται και με πτώση των επιπέδων της τεστοστερόνης.
Η κυκλοφωσφαμίδη, η βινκριστίνη και η σισπλατίνη μπορεί να προκαλέσουν περιφερική νευροπάθεια στην αισθητική και στην αυτόνομη μοίρα του νευρικού συστήματος με αποτέλεσμα μειωμένη αισθητικότητα, στυτική δυσλειτουργία και οργασμική διαταραχή. Περιφερική νευροπάθεια μπορεί να προκαλέσει και η βορτεζομίμπη και η θαλιδομίδη. Η περιφερική νευροπάθεια από βορτεζομίμπη και θαλιδομίδη μπορεί να είναι αναστρέψιμη μετά τη διακοπή της χημειοθεραπείας αλλά αυτό δεν είναι εγγυημένο.
Η θαλιδομίδη και λεναλιδομίδη μπορεί να προκαλέσουν υποθυρεοειδισμό. Ο υποθυρεοειδισμός μπορεί να προκαλέσει στυτική δυσλειτουργία, μειωμένη σεξουαλική επιθυμία και υπογονιμότητα. Επίσης ο υποθυρεοειδισμός μπορεί να προκαλέσει κόπωση και αύξηση του σωματικού βάρους τα οποία επίσης επιβαρύνουν τη σεξουαλική λειτουργία. Η χρήση της θαλιδομίδης και της λεναλιδομίδης έχει περιορισμούς γιατί η θαλιδομίδη προκαλεί τερατογένεση στους ανθρώπους και η λεναλιδομίδη το ίδιο σε πιθήκους. Επιβάλλεται η χρήση αντισύλληψης η οποία μπορεί να προκαλέσει άγχος και μειωμένη σεξουαλική ευχαρίστηση.
Η χορήγηση κορτιζόνης (δεξαμεθαζόνη, πρεδνιζολόνη) σε ασθενείς με πολλαπλό μυέλωμα προκαλεί διαταραχή της έκκρισης των οιστρογόνων και των ανδρογόνων με αποτέλεσμα μειωμένη σεξουαλική επιθυμία, πόνο στην κολπική επαφή και στυτική δυσλειτουργία. Επιπλέον η χορήγηση κορτιζόνης μπορεί να προκαλέσει σάκχαρο, ηλεκτρολυτικές διαταραχές και αλλαγές στη διάθεση. Οι ασθενείς μπορεί να πάρουν βάρος ή να έχουν τριχόπτωση τα οποία επίσης επηρεάζουν αρνητικά τη σεξουαλική διάθεση.
Μπορεί να σας ενδιαφέρουν επίσης:

No comment